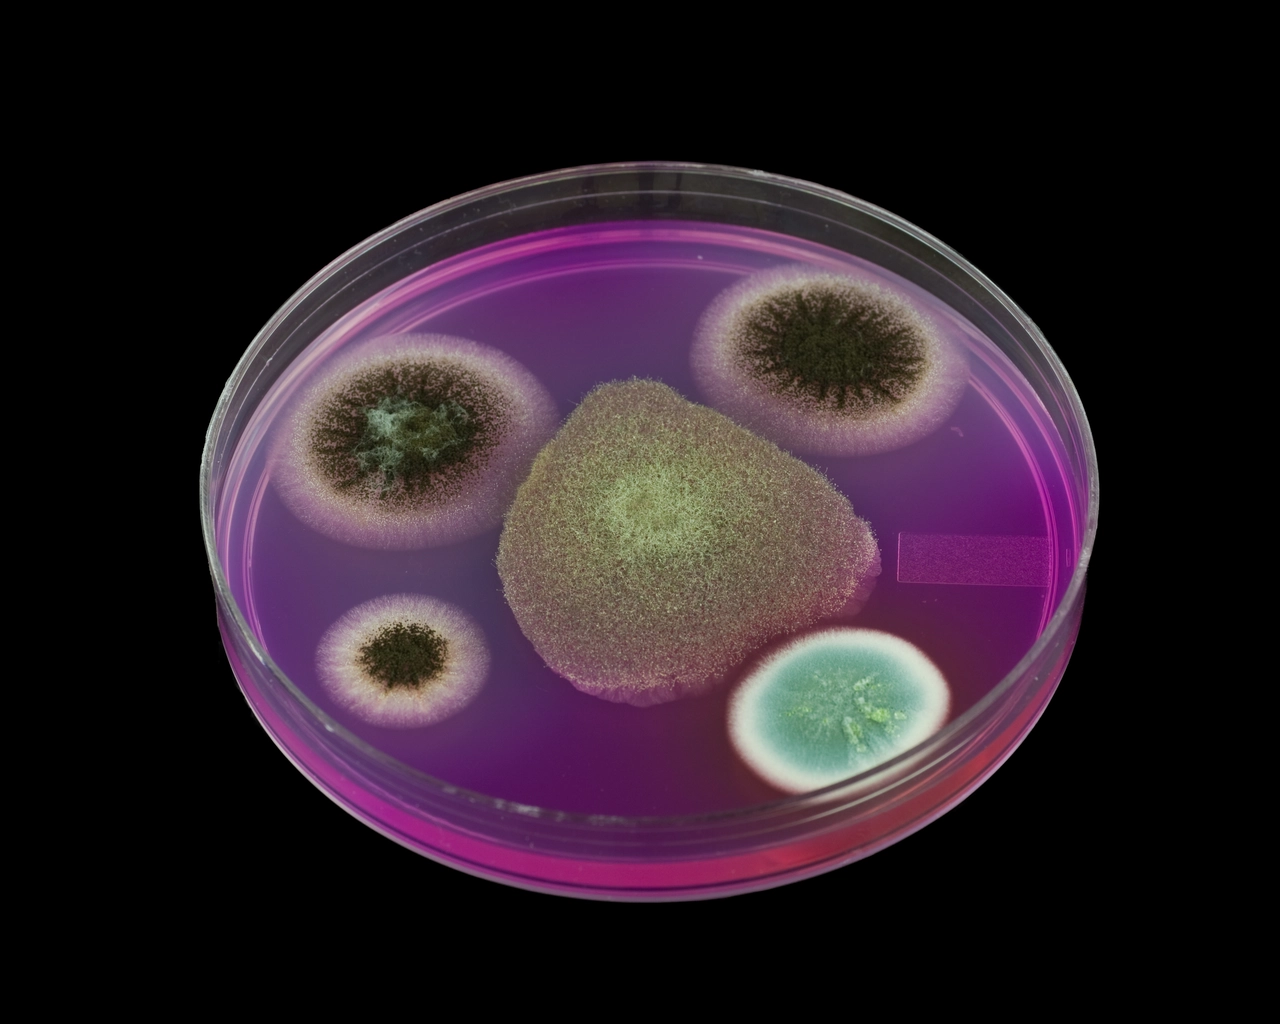
Non solo nell’intestino: ecco dove si nasconde davvero la tua flora batterica

Non immagini quanto l’infermiere sia fondamentale per la tua salute: ecco come ti protegge
Quando si pensa a chi si prende cura della nostra salute, spesso la mente si sofferma sulla figura del medico. Tuttavia, il ruolo dell’infermiere si rivela cruciale, risultando molto più articolato e fondamentale di quanto comunemente si creda. L’infermiere non solo è il primo punto di contatto in tantissimi percorsi di cura, ma svolge una … Leggi tutto